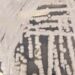
fiocruz-e-pasteur-vao-pesquisar-sobre-danos-dos-fungos-no-ser-humano

A criação de uma cadeia regional de produtos para a saúde no âmbito do Mercosul foi sugerida pela Fundação Oswaldo Cruz (Fiocruz) como uma medida para reduzir a dependência externa. Por meio dessa cadeia, poderia ser garantida a produção de insumos importantes que hoje só são obtidos pelos países do bloco recorrendo ao mercado internacional.
A proposta foi defendida pelo vice-presidente de Produção e Inovação em Saúde da Fiocruz, Marco Krieger, durante a reunião do Comitê Ad Hoc para Promover a Expansão da Capacidade Produtiva Regional de Medicamentos, Imunizações e Tecnologias em Saúde. O comitê foi criado em 2021 e é uma instância do Mercosul cujo objetivo é discutir caminhos para a integração entre os diferentes países do bloco e para o enfrentamento de problemas comuns relacionados com o acesso a medicamentos, vacinas e tecnologias.
Notícias relacionadas:
- Lula e Macron conversam sobre acordo entre Mercosul e União Europeia.
- Acordo Mercosul-UE inibe indústria brasileira, alertam especialistas .
- Lula: exigências da União Europeia para acordo com Mercosul são ameaça.
Segundo informou a Fiocruz, Krieger defendeu uma atuação conjunta, em que a produção não precisasse ser país a país, mas aproveitando as capacidades de cada Estado-membro. Ele defendeu ainda que sejam mapeadas oportunidades para laboratórios públicos e privados, bem como as deficiências e as áreas em que há problemas sérios de suprimentos e que necessitam de estratégias específicas.
“Na reunião, também foi discutida a formação de uma lista de produtos de saúde estratégicos para a região. Esta lista deve ser encaminhada depois aos ministros da Saúde para ver a viabilidade de pesquisa, desenvolvimento e produção”, informou a Fiocruz.
A reunião ocorreu nos últimos dois dias, em Buenos Aires. Estiveram presentes representantes de Brasil, Argentina, Paraguai e Uruguai.

Comente usando o Facebook